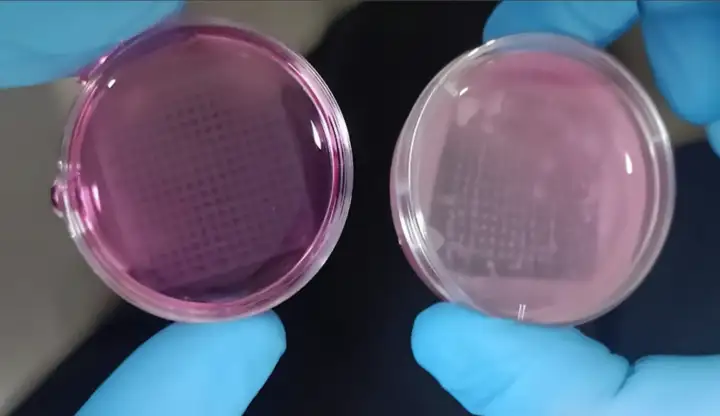

3D-кожа может заменить тестирование косметики на животных
Многих людей беспокоит то, что косметика и лекарства часто испытываются на животных, поскольку это не самая гуманная деятельность. Поэтому исследователи из австрийского Технологического университета Граца при поддержке коллег из Индии разработали особый гидрогелевый состав, включающий живые клетки кожи. Распечатанная на 3D-принтере, эта комбинация в итоге превращается в настоящую ткань, на которой можно тестировать новую косметику.
Гидрогель — это по сути синтетический эквивалент биологической ткани, который выступает матрицей для живых клеток. Благодаря его структуре и изобилию воды в нём клетки свободно размножаются на поверхности материала, поэтому сперва учёные распечатывают гидрогелевую подложку, а затем внедряют в неё клеточные культуры.
Напечатанные на 3D-принтере структуры, которые в итоге развиваются в кожную ткань.© Manisha Sonthalia / Vellore Institute of Technology
Напечатанные на 3D-принтере структуры, которые в итоге развиваются в кожную ткань.© Manisha Sonthalia / Vellore Institute of Technology
Правда, это довольно сложный процесс ввиду хрупкости материала: за клеточной культурой необходимо следить в течение двух-трёх недель, чтобы она была стабильной. На этом этапе ткань развивается и начинает имитировать трёхслойную структуру и биомеханику человеческой кожи, а затем из готовой имитации можно получить нетоксичный слепок.
Стоит отметить, что это далеко не первое такое изобретение, поскольку косметическая компания L'Oreal уже много лет назад разработала схожую реконструкцию кожи для тестирования, которая получила название Episkin. А в 2015 году L'Oreal объединилась с фирмой 3D-биопечати Organovo, чтобы найти способ, как распечатать на 3D-принтере искусственную кожу.